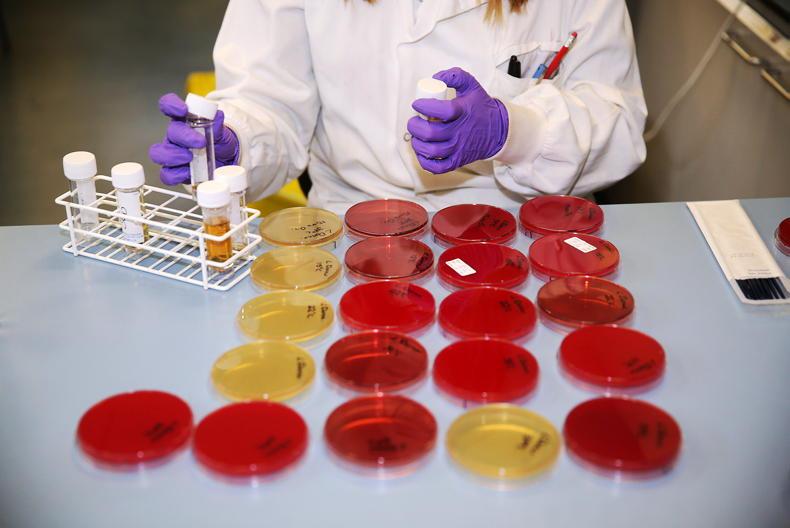

HORSE owners and breeders are being urged to keep a close eye on their bloodstock following an outbreak of Equine herpesvirus 1 (EHV1) in continental Europe.
The virus has already claimed six equine lives in Spain, all connected to a recent international show jumping event. Similar events have been cancelled in 10 countries across Europe in a bid to contain the spread of the disease.
The Irish Field understands that two horsetrucks returned to Ireland from the Spanish event and those horses are under tight quarantine and surveillance by the Department of Agriculture. Online reports that there were “hundreds” of Irish horses at the event are incorrect and possibly refer to the presence of 190 Irish-bred horses who were competing there.
Shane O’Dwyer, CEO of the Irish Thoroughbred Breeders’ Association, said: “Since the outbreak we are working closely with Horse Sport Ireland and the Department of Agriculture, who have been hugely supportive. It is very important that anyone bringing in horses from the continent is especially vigilant at the moment. They must comply with the Codes of Practice and have two PCR (swab) tests taken at the end of quarantine.”
Virus spread
Professor Ann Cullinane, head of virology at the Irish Equine Centre, said: “Outbreaks of Equine herpesvirus are, thankfully, fairly rare in Ireland but they do occur and can result in fatalities. Veterinary clinicians are familiar with Equine herpesvirus disease and the Irish Equine Centre has the capacity to do the testing required to confirm and assist in the management of the disease.
“Unfortunately, in the case of the current outbreak at the showgrounds in Valencia, Spain, the movement of horses before restrictions were implemented appears to have facilitated virus spread to other countries including France, Germany and Belgium.
“This is primarily a disease of adult horses, and mares seem to be more susceptible than stallions or geldings. It is advisable to avoid high stocking densities particularly in barns, poor ventilation, confinement and situations that precipitate bullying or induce stress.”
It has been reported that several horses who died in Spain were vaccinated. However, there is scientific evidence that the vaccines reduce virus shedding, respiratory signs and the incidence of abortion. Cullinane said: “Thus, vaccination of pregnant mares is recommended and some owners may want to consider vaccinating other horses in an effort to decrease virus transmission on their premises.”
In the majority of cases the neurological signs are preceded by a temperature spike, loss of appetite, lethargy or mild respiratory disease. Thus, any horse that appears off form should be monitored and if possible, isolated. The most common neurological signs are hind limb incoordination and urinary incontinence but an affected horse may collapse and be unable to rise.
Isolation
If there is any reason to suspect Equine herpesvirus infection, isolate the horse, stop movement on or off the premises, maintain or subdivide existing groups (don’t mix), and seek veterinary advice. A nasopharyngeal swab and blood samples should be submitted to the Virology Unit of the Irish Equine Centre.
In the event that the disease is confirmed, the Centre can assist with ongoing monitoring and risk assessment. Strict segregation of groups of horses may confine the virus to a small number of horses and with laboratory testing it may be possible to allow groups of uninfected horses to leave the premises before the outbreak has concluded. With supportive veterinary care, slings and access to pasture as appropriate, affected horses may make a full recovery.
See Irish HorseWorld >> 76-77

This is a subscriber-only article
It looks like you're browsing in private mode
SHARING OPTIONS: